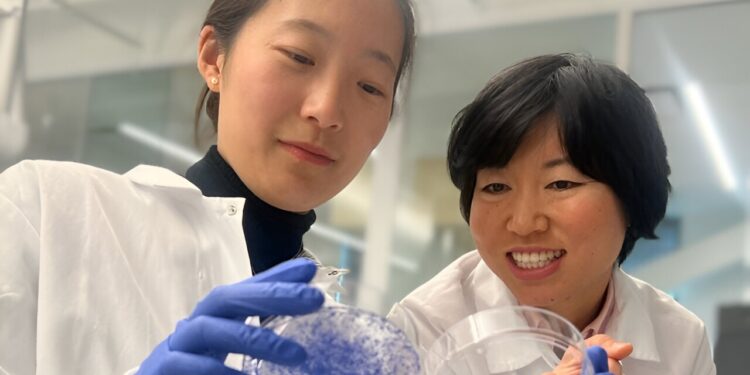
Researchers discover on/off switch for breast cancer metastasis

Songnan Wang (left) and Lingyin Li (right) discovered that a protein called ENPP1 acts as an on/off switch for breast cancer metastasis. High levels of protein lead to a high risk of metastasis (as shown by the cells growing in the left box), while low levels lead to no metastasis (as shown by the absence of cells growing in the box on the left). of right). Credit: Lingyin Li and Songnan Wang
Despite their promise, immunotherapies fail to treat many cancers, including more than 80% of some of the most advanced breast cancers. And many of the patients who respond to treatment eventually develop metastases. New research from Stanford University and the Arc Institute has revealed a better way to predict and improve patient responses.
A team led by Lingyin Li, associate professor of biochemistry at Stanford and Arc Core Investigator, discovered that a protein called ENPP1 acts as an on/off switch that controls breast cancer’s ability to resist immunotherapy and metastasize .
The study, published December 20 in the Proceedings of the National Academy of Sciencesshowed that ENPP1 is produced by cancer cells and by healthy cells in and around the tumor, and that high levels of ENPP1 in patients are linked to resistance to immunotherapy and subsequent metastasis.
The research could lead to new, more effective immunotherapies and help clinicians better predict patients’ response to existing drugs. “Our study should offer hope to everyone,” said Li, who is also a researcher at the Sarafan ChEM-H Institute.
Thaw cold tumors
Immunotherapies, such as pembrolizumab (Keytruda), work by blocking an immune interaction between a cancer cell and a T cell, a type of immune cell. However, for this to be effective, T cells must enter the tumor. So-called “hot” tumors, such as melanoma and a subset of lung cancer, can be treated with immunotherapy, but many others, such as breast and pancreatic cancers, are “cold,” lacking infiltration of T lymphocytes.
In his quest to warm up cold tumors, Li started with cGAMP, a molecule that cells produce when their DNA is damaged, which happens when a cell becomes cancerous. If left intact, cGAMP activates an immune response through what’s called the STING pathway, which can help make a tumor hot.
Li had previously discovered that cGAMP is exported outside of cells, but often, before it can trigger a response, a protein called ENPP1 absorbs these molecular “danger” signals. ENPP1, she proposed, helped keep tumors cold.
High levels of ENPP1 correlate with poor prognosis in many cancers, but the protein can perform many actions in the body. So Li set out to determine whether its ability to chew cGAMP was behind its clinical importance.
An on/off switch
Li began collaborating with two professors at the University of San Francisco: Hani Goodarzi, also a new principal investigator at the Arc Institute, and Laura Van’t Veer, a clinician leading the groundbreaking I-SPY 2 trial on breast cancer. ENPP1 levels naturally vary among individuals, so the team looked at data from patients in the I-SPY 2 trial to see how responses to pembrolizumab varied with ENPP1 levels at diagnosis .
The results were astounding. Patients with high ENPP1 levels had a poor response to pembrolizumab and a high risk of metastases. Those with low ENPP1 levels had a high response to pembrolizumab and no metastasis. ENPP1 predicts both response to immunotherapy and likelihood of relapse.
Two things suddenly became clear: ENPP1 was essential in metastases, not just in primary tumors; and that they should be interested in ENPP1 in healthy cells, not just in cancer cells.
“Using the best molecular scalpels developed in our lab, I was excited to dig deeper and understand exactly how ENPP1 has such a dramatic influence on clinical outcomes,” said Songnan Wang, MD-Ph.D. student in biochemistry, researcher at Arc and first author of the article.
In a series of mouse studies, Wang proved that completely eliminating ENPP1 or eliminating only its cGAMP-chewing ability in normal and cancer cells produced exactly the same result: decreased tumor growth. and a reduction in metastases. And the team proved that this was a direct result of removing the STING pathway. They found an on/off switch.
At the top of the waterfall
Immune pathways are often described as “cascades” with a series of signals that trigger downstream actions that ultimately lead to a response.
“For cancers to prevent the immune system from detecting them, they have to build dams that block the signal,” Li said. “We showed that ENPP1 acts like a big dam at the top of the cascade.”
This means that clinicians can use ENPP1 levels to better determine the appropriate treatment for breast cancer patients. It also means that drugs that destroy the ENPP1 barrier could make existing therapies more effective – and several ENPP1 inhibitors are already in clinical development.
Although this work focused on breast cancer, Li believes ENPP1 plays a critical role in other types of “cold” tumors.
“I hope to inspire clinicians who treat cancers, including lung cancer, glioblastoma and pancreatic cancer, to study the role of ENPP1 in patient outcomes,” Li said.
Li is also a member of Stanford Bio-X and the Stanford Cancer Institute. Other Stanford co-authors include Alby Joseph and Valentino Sudyaryo (of Stanford and Arc); Volker Böhnert, Gemini Skariah and Xuchao Lyu (from Stanford). Other co-authors are from the University of California, San Francisco and Arc.
More information:
Songnan Wang et al, ENPP1 is an innate immune checkpoint of the cGAMP–STING anticancer pathway in breast cancer, Proceedings of the National Academy of Sciences (2023). DOI: 10.1073/pnas.2313693120
Provided by Stanford University
Quote: Researchers discover on/off switch for breast cancer metastases (December 20, 2023) retrieved December 20, 2023 from
This document is subject to copyright. Apart from fair use for private study or research purposes, no part may be reproduced without written permission. The content is provided for information only.